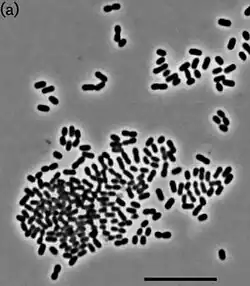

Bryobacter
| Bryobacter | ||
|---|---|---|
![]() | ||
| Taxonomía | ||
| Dominio: | Bacteria | |
| Reino: | Pseudomonadati | |
| Filo: | Acidobacteriota | |
| Clase: | Terriglobia | |
| Orden: | Bryobacterales | |
| Familia: | Bryobacteraceae | |
| Género: | Bryobacter | |
| Especie: | Bryobacter aggregatus | |
Bryobacter es un género de bacterias gramnegativas de la familia Bryobacteraceae. Actualmente contiene una sola especie: Bryobacter aggregatus. Fue descrita en el año 2010. Su etimología hace referencia a bacteria asociada al musgo. El nombre de la especie hace referencia a la formación de agregados.[1] Es aerobia, inmóvil y con cápsula. Tiene un tamaño de 0,5-0,8 μm de ancho por 0,8-1,3 μm de largo. Forma colonias pequeñas, lisas, circulares, con márgenes enteros y no pigmentadas. Catalasa positiva y oxidasa negativa. Temperatura de crecimiento entre 4-33 °C, óptima de 22-28 °C. Es resistente a ampicilina, cloranfenicol, lincomicina, kanamicina y neomicina. Sensible a estreptomicina, novobiocina y gentamicina. Tiene un contenido de G+C de 55,5%. Se ha aislado de turba del musgo Sphagnum, en Tomsk, Rusia.
Referencias
- ↑ Kulichevskaya, Irina S.; Suzina, Natalia E.; Liesack, Werner; Dedysh, Svetlana N. (2010-02). «Bryobacter aggregatus gen. nov., sp. nov., a peat-inhabiting, aerobic chemo-organotroph from subdivision 3 of the Acidobacteria». International Journal of Systematic and Evolutionary Microbiology 60 (Pt 2): 301-306. ISSN 1466-5026. PMID 19651730. doi:10.1099/ijs.0.013250-0. Consultado el 18 de noviembre de 2023.